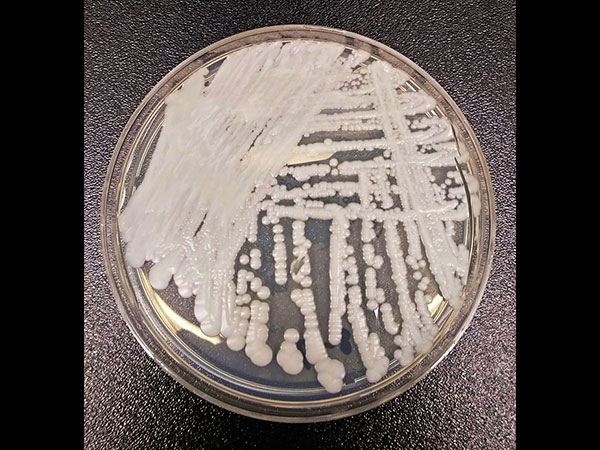
30 से 90 दिनों में हो सकती है मौत

Latest Updates
-
Mangal Gochar 2026: अपनी ही राशि में मंगल का गोचर; इन 4 राशि वालों पर मंडरा रहा है दुर्घटना' का साया -
Somnath Amrit Mahotsav: पीएम मोदी ने सोमनाथ में किया कुंभाभिषेक, जानें 11 तीर्थों के जल का महत्व -
PM Modi की Gold न खरीदने की चर्चा तेज, जानिए किस देश में मिलता है सबसे सस्ता सोना -
Suryakumar Yadav बने पिता, बेटी का नाम रखा 'रिद्धिमा', जानें इसका अर्थ और धार्मिक महत्व -
National Technology Day 2026 Quotes: मिसाइल मैन के वो अनमोल विचार जो आज भी युवाओं को देते हैं प्रेरणा -
Aaj Ka Rashifal 11 May 2026: सोमवार को इन 4 राशियों पर बरसेगी महादेव की कृपा, धन लाभ के साथ चमकेंगे सितारे -
गर्मी में टैनिंग से काली पड़ गई है गर्दन? टेंशन छोड़ें और आजमाएं दादी मां के ये 5 अचूक घरेलू नुस्खे -
Apara Ekadashi 2026: 12 या 13 मई, कब रखा जाएगा अपरा एकादशी का व्रत? जानें पूजा विधि और पारण का समय -
Eid-ul-Adha 2026: 27 या 28 मई, भारत में कब मनाई जाएगी बकरीद? जानें क्यों दी जाती है कुर्बानी -
Mother's Day से पहले सोनम कपूर ने दिया बड़ा सरप्राइज, रिवील किया बेटे का नाम, महादेव से है गहरा नाता
सावधान! दुनियाभर में दबे पांव इस जानलेवा फंगस ने दी दस्तक, दवाइयों का भी नहीं कोई असर
दुनिया भर में एक रहस्यमयी और खतरनाक फंगल इंफेक्शन 'कैंडिडा ऑरिस' (Candida Auris) धीरे-धीरे अपनी जड़े फैलता जा रहा है। इस फंगल इंफेक्शन से डरने की जरुरत इसलिए भी है क्योंकि इससे प्रभावित करीब आधे मरीजों को बचाया नहीं जा सकता है, साथ ही इस पर किसी दवाई का असर होता नहीं दिख रहा है।
डरने वाली बात इसलिए भी है क्योंकि अभी तक इस फंगस का कोई इलाज सामने नहीं आया हैं और इससे ज्यादा खतरनाक बात ये है कि इसकी चपेट में आने से अगर किसी व्यक्ति की मौत भी हो जाएं तो यह फंगस जिंदा रहता है और दूसरों के शरीर में आसानी से प्रवेश कर उन्हें भी संक्रमित बना सकता है। कैंडिडा ऑरिस को सी ऑरिस वायरस के नाम से भी जाना जाता है।

क्या है सी ऑरिस, पहले ये जान लें
ये एक ऐसा खतरनाक फंगस है जो ब्लडस्ट्रीम में प्रवेश करने के बाद शरीर में खतरनाक इन्फेक्शन पैदा कर सकता है जिससे जान जा सकती है। वैज्ञानिकों ने वर्ष 2009 में सबसे पहले जापान के एक मरीज में इसकी पहचान की थी। पिछले कुछ सालों में इसके मामलें दुनियाभर में सामने आए हैं।
यूएस में इस खतरनाक फंगस के 587 केस सामने आ चुके हैं। इस संदर्भ में भारत की बात करें तो 2011 में इसका पहला मामला सामने आया था।

दवाईयां भी बेअसर
फंगल इन्फेकशन दो प्रकार के फंगस के ग्रुप के कारण होते हैं: ऐल्बिकैंस (albicans) और नॉन-ऐल्बिकैंस (non-albicans)। ऐल्बिकैंस पर ऐंटीफंगल का असर होता है, लेकिन चिंता का विषय यह है कि कैंडिडा ऑरिस नॉन-ऐल्बिकैंस कैटगिरी में आता है, यानी ऐसा फंगस जिस पर ऐंटीफंगल दवाई बेअसर है। यही वजह है कि इस फंगस से संक्रमित मरीजों के बचने के संभावना बहुत कम होते हैं।

लक्षण
बुखार, दर्द और कमजोरी के लक्षण यूं तो आम लगते हैं लेकिन अगर किसी व्यक्ति का इम्यून सिस्टम कमजोर है और उसे यह फंगस आसानी से चपेट में ले सकता है।
30 से 90 दिनों में हो सकती है मौत
यह फंगस अपने आप भी बहुत ही खतरनाक और जानलेवा है, ये आसानी से लोगों को अपनी चपेट में ले सकता है। ये संक्रमित मरीज, उपकरण, खाद से उपजाई सब्जी और खुला मांस के जरिए आसानी से फैलता है। रिपोर्ट की मानें तो सी ऑरिस से पीड़ित ज्यादात्तर मरीजों ने 30 से 90 दिनों के भी भीतर दम तोड़ देते हैं हैं।

अभी तक नहीं है कोई जानकारी
वर्ष 2009 में इस फंगस से जुड़ा पहला मामला सामने आया था, तब से लेकर अभी तक इस फंगस के बारे में बहुत ही कम लोगों को मालूम है। इसकी सबसे बड़ी वजह इसे अभी तक गोपनीय बनाकर रखा जा रहा है। इसके पीछे अस्पताल और स्थानीय सरकार का तर्क है कि आउटब्रेक के बारे में कोई भी जानकारी देने पर उन्हें इन्फेक्शन का केंद्र माना जाने लगेगा। यहां तक कि सेंटर्स फॉर डिसीज कंट्रोल भी राज्यों के साथ उनके अनुबंध के कारण प्रभावित अस्पताल या उसकी लोकेशन के बारे में खुलासा नहीं कर स

इलाज करने वालों को भी डर
कैंडिडा ऑरिस से संक्रमित मरीजों का इलाज करने वालों को भी अपनी सुरक्षा का डर रहता है। क्योंकि ये फंगस अपने आप भी बहुत विकसित है जो संक्रमित व्यक्ति की मुत्यु होने के बाद भी जीवित रहकर किसी अन्य को अपनी चपेट में ले सकता है। अभी इसे खत्म करने के लिए कोई कारगार वैक्सीन ये दवा नहीं बनने की वजह से दुनियाभर के डॉक्टर्स भी इसका इलाज देने में असहाय हैं। हालांकि इस रहस्यमयी फंगस को लेकर कई बातें आपस में उलझी हुई है कि आखिर ये फंगस कहां से आया और इससे ज्यादा इसे फैलने से कैसे रोका जाए इस पर ध्यान दिए जाने की ज्यादा जरूरत है। इसके फैलने से रोकने और ट्रीटमेंट को लेकर रिसर्च शुरू की जा चुकी है।



Click it and Unblock the Notifications